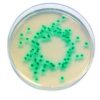

| Tên sản phẩm: | (-) Riboflavin 10G |
| Tên gọi khác: | Lactoflavin, Vitamin B2 |
| Hãng – Xuất xứ: | Himedia – Ấn Độ |
| Code: | CMS181-10G |
| CAS: | 83-88-5 |
| Công thức hóa học: | C17H20N4O6 |
| Ứng dụng: |
– Trong y học, Riboflavin (vitamin B2) là một loại vitamin B. Nó là thành phần trung tâm của cofactor FAD và FMN và là thành phần cần thiết cho nhiều loại phản ứng enzym flavoprotein bao gồm cả việc hoạt hóa các vitamin khác. |
| Tính chất: |
– Trạng thái: Dạng rắn – Màu sắc: màu vàng – Khối lượng mol: 376.36 g/mol. – Độ tan trong nước: 33mg/ml |
| Thành phần: |
– Độ tinh khiết: 99.00 – 102.00% |
| Bảo quản: | – Bảo quản ở nhiệt độ dưới +30°C |
| Quy cách đóng gói: | – Chai 10g |
Sản phẩm tham khảo:
| Code | Quy cách |
| CMS181-10G | Chai 10g |
| CMS181-25G | Chai 25g |

Đánh giá
Chưa có đánh giá nào.